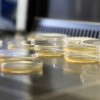
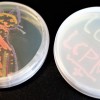

Le mois de la santé et de la recherche médicale a lieu chaque année, durant tout le mois de mars. À Votre Santé vous propose un grand choix d’événements : conférences, expositions, projections et spectacles traitant de la santé, du corps et de ce qui l’entoure.
Mercredi 15 mars, c’est au Laboratoire de Chimie Physique et Microbiologie pour les Matériaux et l’Environnement, que de nombreux curieux se sont retrouvés.
Au programme : moment de convivialité, autour d’un café, pour appréhender l’origine des projets et les missions du labo dans lequel ils venaient de rentrer.
Après une courte présentation didactique, le Pr Christophe Merlin a présenté les différents lieux du laboratoire où les microbes sont prélevés, observés, analysés. Ces derniers, que nous portons en et sur nous, ont une vie qu’on ne soupçonnerait pas… dans la nature.
Dans les sols, les cours d’eau, ils rencontrent d’autres microbes, et vivent et échangent des informations génétiques avec eux. Pour mieux comprendre les conséquences sur leur résistance aux antibiotiques, des chercheurs et chercheuses ont ainsi fait du suivi de ces microbes leur métier.
Et c’est ce quotidien de chercheurs que les visiteurs du jour ont pu découvrir, le temps de leur visite !